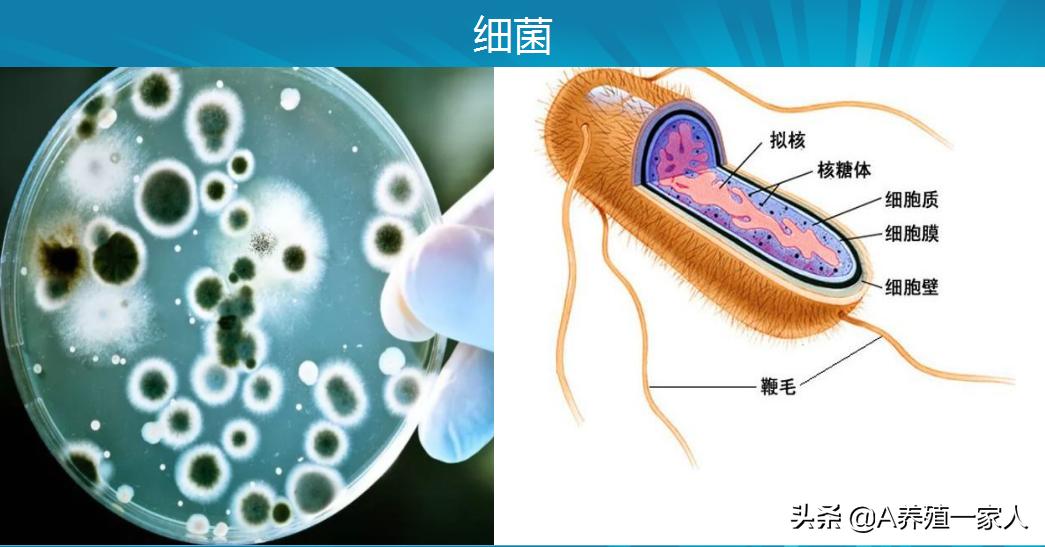
禽大肠杆菌特效药,哪种中药对鸡大肠杆菌有效

人们最常使用的抗菌药就是抗生素,中国是抗生素使用的第一大国。
抗生素的抗菌作用明显,能够直接作用于菌体细胞,干扰细胞的代谢,从而抑制细菌的生长或致其死亡。
由于抗生素卓越的抗菌作用,以及人们对它的过度信赖,导致无论得了哪种疾病都要来点抗生素,这也导致我国有很大一部分抗生素的使用是处于滥用状态。

滥用抗生素会导致肝肾功能损害、菌群失调、抗生素相关性腹泻,以及细菌的耐药性增加、二重感染,甚至是延误病情导致死亡等严重不良反应的发生;因此国家对于抗生素的使用管理越来越严格。

自国家农业部发布第194号公告,公告提出:为了维护我国动物源性食品安全和公共卫生安全,决定停止生产、进口、经营、使用部分药物饲料添加剂,并对相关管理政策作出调整。“禁抗”的枪声已经打响。
细菌病在养殖周期中,危害严重,且常和其它疾病并发、继发感染,因此临床防治细菌病,显得尤为重要。
自国家农业部发布第194号公告,公告提出:为了维护我国动物源性食品安全和公共卫生安全,决定停止生产、进口、经营、使用部分药物饲料添加剂,并对相关管理政策作出调整。“禁抗”的枪声已经打响。
细菌病在养殖周期中,危害严重,且常和其它疾病并发、继发感染,因此临床防治细菌病,显得尤为重要。
特点
1、溶菌酶:是一种碱性球蛋白,活性稳定,耐热耐酸强,通过溶解细菌细胞壁而起到抗菌作用,同时提高机体免疫力。
2、炎琥宁(穿心莲内酯): 现代生产工艺提取穿心莲有效成分,抗菌消炎抗病毒,对炎症渗出和上呼吸道感染具有强大的抑制作用。
3 、优生素: 采用现代生产工艺,用植物原料提取有效成分,具有强大的抗菌消炎作用。
4 、诸药共用,协同抗菌消炎抗病毒,提高免疫力,对各种细菌感染尤其是在现有食品安全无抗养殖大环境下的致病性大肠杆菌、沙门氏菌、巴氏杆菌、金黄色葡萄球菌等细菌性疾病有强大的杀灭作用。
溶菌酶:是一种能水解细菌中多糖的碱性酶,能导致细胞壁(肽聚糖)破裂内容物逸出而使细菌溶解。
该酶广泛存在于人体多种组织中,鸟类和家禽的蛋清、哺乳动物的泪、唾液、血浆、乳汁等液体,其中以蛋清含量最为丰富。

穿心莲内酯:为天然植物穿心莲主要有效成份,具有清热解毒,消炎止痛之功效,对细菌与病毒性上呼吸道感染及痢疾有特殊疗效,无论是“病毒”、“细菌”,还是双重感染均有显著治疗效果。
天然抗生素,必为首选!

绿色溶菌 无抗养殖:溶菌1号:让您的鸡和蛋不再担心药残抽检。
不能用抗生素时最好的选择!
关注【养殖一家人】,了解更多养殖详情如果您有更多养殖问题,可以随时咨询我,点这里,获取联系方式,一次咨询,终生免费技术指导!!!
祝您养殖无忧,养殖路上一帆风顺!!!